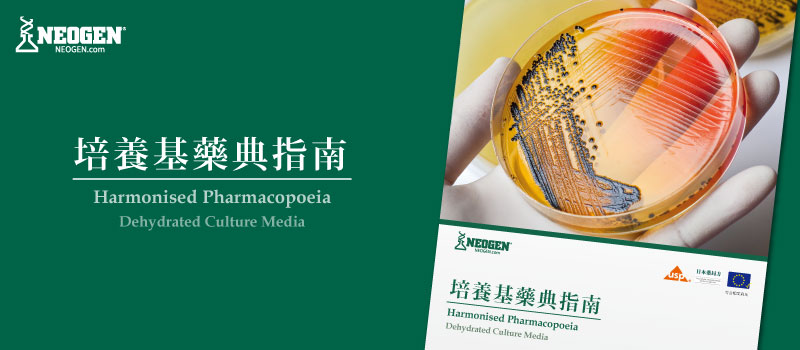

2022/04/19 Neogen 培養基藥典指南-中文版
|
| - 最 完 整 的 培 養 基 藥 典 指 南 - |
| Neogen NCM 藥典專用17種參考微生物專用培養基,完全遵循USP,EP (USP<61>/Ph.EUR.2.6.12 USP<62>/Ph.EUR.2.6.13),日本藥局三調合的成分與配方生產製造,針對藥廠,生技醫業NCM專業粉末培養基,確保從原料製程,環境監控以及最終產品的安全和品質,並滿足品質系統專業的需求以及法規的遵循,透過NCM的把關,將您公司高品質的產品,優秀的商譽,呈現給予您寶貴的客戶。 | |
| 無論在物理性、化學性、微生物生長表現都符合歐洲39個國家、世界120以上的國家,承認其應用,包含: | |
|
• |
無菌測試 |
| • | 微生物計數,限量試驗 |
| • | 特定微生物測試 |
| • | 抗微生物敏感性試驗 |
| • | 藥廠水質微生物檢測 |
| • | 消毒效能檢測 |
| • | 環境微生物監控 |
| ► | Neogen HP 培養基 | ||
| Neogen 開發出適用於製藥應用的全系列脫水培養基(DCM),其配方與性能皆符合2020 年1 月公告的第10 版歐洲藥典(EP),並可從技術資料表(Technical Specification Sheets) 及 檢驗證明書(Certificates of Analysis) 驗證培養基產品的符合性。 | |||
 |
 |
 |
|
| Sterility Testing 無菌性試驗 |
Examination of Non-Sterile Products 非無菌產品檢測 |
Cultivation of Microorganisms 微生物培養 |
|
| Neogen 培養基非常適用於製藥產業,舉凡藥物生產、化妝品、消毒劑、臨床產品到專業合約實驗室都可使用,另有一系列輔助性培養基(complementary media),如R2A Agar(NCM0076)、 BCSA(NCM0209),可支持並應用在上述試驗中。 | |||
| ► | 為什麼要選擇HP Compliant 培養基? | ||
| 使用符合最新版歐洲藥典,USP 以及日本藥局方對配方與效能要求的培養基來進行試驗,可確保您的產品符合嚴格的品質與通過安全準則的把關。 | |||
► 為何您要使用NEOGEN Culture Media ?
► Neogen 培養基指南-中文版













